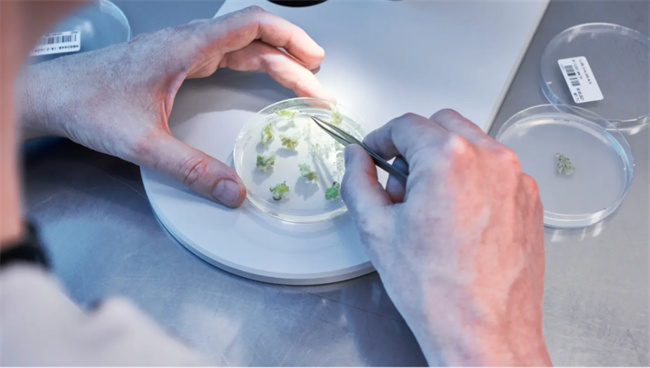

智種資訊在線:近日舜豐生物與德國KWS種業(yè)達成全球授權合作,助推歐洲良種育種進程;齊禾生科也近日攜手科迪華農(nóng)業(yè)科技,協(xié)同開發(fā)抗逆、營養(yǎng)強化型作物,為全球農(nóng)業(yè)可持續(xù)發(fā)展注入中國科技新動能。這兩則合作幾乎在同一時間公布,被業(yè)內(nèi)稱為中國基因編輯技術出海的“雙響炮”。它不僅意味著中國企業(yè)的技術實力得到了國際頭部公司的認可,也表明基因編輯正逐步走向全球主流舞臺。
第三次育種革命,基因編輯的時代價值
基因編輯技術正引領全球育種的第三次革命。它以前所未有的精準度和效率優(yōu)化作物基因組,顯著縮短育種周期,全面提升抗病性、抗逆性與營養(yǎng)品質。隨著氣候變化給農(nóng)業(yè)帶來持續(xù)壓力,該項技術的重要性愈發(fā)凸顯。值得注意的是,長期以來嚴格執(zhí)行轉基因法規(guī)的歐洲,近年對基因編輯態(tài)度漸趨開放。未來若政策持續(xù)松動,將為企業(yè)合作釋放巨大潛力——正如舜豐生物與德國KWS的合作,有望迎來更廣闊的發(fā)展空間。

科迪華農(nóng)業(yè)科技作為基因編輯領域的領軍者,已在該技術應用方面取得重要進展。其利用CRISPR工具精準定位并組合玉米中天然存在的抗病基因,模擬自然變異過程,加速開發(fā)抗逆性強、產(chǎn)量更高的新品種。這不僅有助于應對干旱與病害,還能提升作物的營養(yǎng)價值,為農(nóng)民增產(chǎn)和農(nóng)業(yè)可持續(xù)發(fā)展提供科技支撐??频先A的研究證實,通過基因編輯復制天然抗病機制,是邁向綠色農(nóng)業(yè)未來的關鍵一步。
中國技術崛起:科研與產(chǎn)業(yè)雙輪驅動
2012年CRISPR技術的誕生,帶動基因編輯領域飛速發(fā)展,相關研究論文、專利數(shù)量呈現(xiàn)指數(shù)增長趨勢,2014年至2023年基因編輯領域共發(fā)表了約70810篇論文,論文量從2014年的2983篇增長到2023年的10303篇,復合年增長率(CAGR)為13.20%,展現(xiàn)出巨大的發(fā)展?jié)摿?。從重要研究機構來看,全球論文發(fā)表量排名前20位的機構中,有我國機構7所,為中國科學院、中國農(nóng)業(yè)科學院、上海交通大學、浙江大學、華中農(nóng)業(yè)大學、中山大學、復旦大學,體現(xiàn)了國內(nèi)機構在基因編輯領域的較強研究實力。

在2001至2023年間全球提交的17,175個專利家族中,中國和美國是優(yōu)先權專利申請的主要提交地,分別貢獻了7,945件(占比46.25%)和6,835件(占比39.80%)。其余申請主要通過歐洲專利局(479件,2.79%)、專利合作條約程序(367件,2.14%)以及英國(266件,1.55%)等途徑提交。自基因編輯技術興起以來,中國在該領域的專利布局不斷加速,并于2020年在專利申請數(shù)量上超越美國,成為全球基因編輯技術創(chuàng)新的重要主導力量。

舜豐生物、齊禾生科、艾迪晶生物、未米生物等“四小龍”快速崛起,這幾家企業(yè)聚焦于作物育種和生物技術研發(fā),依托自主可控的基因編輯工具體系,不僅在關鍵技術環(huán)節(jié)實現(xiàn)了突破,還在市場應用端展現(xiàn)出強勁潛力。

它們的崛起,正在重塑國內(nèi)基因編輯產(chǎn)業(yè)格局,并推動中國在這一前沿領域加快向全球價值鏈的高端邁進。
亞太地區(qū)是基因編輯戰(zhàn)略要地
2022年被譽為“中國生物育種元年”,政策與資本雙雙加碼生物育種賽道。據(jù)統(tǒng)計,2024年全球基因編輯市場規(guī)模已達93億美元,預計將從2025年的107.7億美元增長至2034年的401億美元,期間復合年增長率高達15.74%。

對此,中國科學院院士、北京大學前校長、著名植物生理學家許智宏表示:“基因編輯育種具有顯著優(yōu)勢,能夠快速培育出高產(chǎn)、高附加值的優(yōu)良品種?!掇r(nóng)業(yè)用基因編輯植物評審細則(試行)》的發(fā)布和首批安全證書的頒發(fā),讓我們看到了民族種業(yè)振興的真正希望。”

預計亞太地區(qū)將成為基因編輯市場中增長最快的區(qū)域。中國、日本和韓國等國家持續(xù)加大研發(fā)投入,匯聚了大量處于技術前沿的學術機構與生物技術企業(yè)。另一方面,中國作為全球最大的種業(yè)市場,正吸引更多國際企業(yè)加速本土化布局。KWS與科迪華選擇在亞太開展合作,不僅體現(xiàn)了技術與產(chǎn)業(yè)化深度融合的趨勢,也旨在共同開發(fā)適應多樣化農(nóng)業(yè)體系的區(qū)域解決方案,推動基因編輯產(chǎn)品在全球市場安全、有序落地。
全球格局:巨頭與本土力量的博弈
CRISPR 技術不僅讓科研人員能夠像“分子剪刀”般精準改寫作物基因,還顯著縮短了育種周期,降低了試錯成本。對企業(yè)而言,這意味著新品種從實驗室走向田間的速度前所未有地快,誰能率先掌握,誰就能在未來種業(yè)競爭中占得先機。更為重要的是,基因編輯正在打破農(nóng)業(yè)創(chuàng)新長期被少數(shù)巨頭壟斷的格局。其普及性與高效性正重塑行業(yè)競爭邏輯,使跨國巨頭與本土龍頭企業(yè)都將其視作決定未來競爭力的戰(zhàn)略高地。
從專利格局看,科迪華(Corteva)憑借從 Broad、加州大學伯克利分校(CVC)、維也納大學、維爾紐斯大學等處獲得的大宗作物及植物全應用的獨占許可,再加上廣泛的非獨占授權,已在農(nóng)業(yè)基因編輯領域構筑起強大的專利壁壘,掌握著全球產(chǎn)業(yè)競爭的主導權。相比之下,拜耳-孟山都、先正達、巴斯夫等巨頭則更多聚焦特定作物或應用場景,而 Vilmorin、國際水稻研究所、JR Simplot 等機構則深耕特色作物與性狀改良。

中國企業(yè)雖起步較晚,但憑借工具創(chuàng)新與應用突破,正逐步嵌入全球合作網(wǎng)絡,并在亞太市場展現(xiàn)出日益增強的影響力。
智種評論
中國基因編輯企業(yè)的“雙響炮”出海,既是技術實力走向全球的標志,更是對國內(nèi)農(nóng)業(yè)產(chǎn)業(yè)的警示:未來競爭不僅是技術突破的較量,更是速度、應用和全球化能力的比拼。“出海”是生物技術企業(yè)全球化起點,強與否在于核心技術、產(chǎn)業(yè)鏈整合及合規(guī)與品牌力。擔憂不在走出去,而在能否站穩(wěn)、發(fā)聲、盈利。種企應以“政策-技術-市場”為坐標:順政策、破專利、抓剛需,提前布局專利與合作,才能在第三次育種革命中搶占先機。












